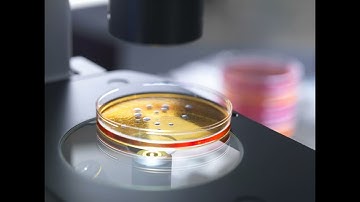
Gene editing - CRISPR- Biological cyborg - A.I take over for the quantum computer.

⬇ DOWNLOAD NOW
Kalau muncul iklan pop-up, tutup lalu klik tombol kembali
Download lagu Quantum Genomics: Where Quantum Computing Meets Genetic Editing secara gratis hanya untuk keperluan promosi. Dukung artis favorit kamu dengan membeli musik original di iTunes atau platform resmi lainnya.
 Genomics with Quantum Computing
Genomics with Quantum Computing
 Quantum-AI Genomics
Quantum-AI Genomics
 27. Gen-AI Computer HPC Meets Gene Editing.
27. Gen-AI Computer HPC Meets Gene Editing.
 Inside Genetic Editing Chambers: The Future of Human Evolution_20251029T1239_genai
Inside Genetic Editing Chambers: The Future of Human Evolution_20251029T1239_genai
 Full Science Documentary Genetics Robotics Quantum Computing Science Documentary
Full Science Documentary Genetics Robotics Quantum Computing Science Documentary
 Quantum Computers Explained: How Quantum Computing Works
Quantum Computers Explained: How Quantum Computing Works
Gene editing - CRISPR- Biological cyborg - A.I take over for the quantum computer.
Gene editing - CRISPR- Biological cyborg - A.I take over for the quantum computer.
 Are quantum computers the future of genome analysis?
Are quantum computers the future of genome analysis?